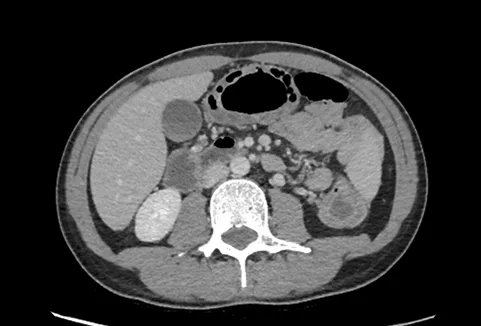

Liens d’intérêt
L’auteur déclare des liens d’intérêt avec Abbvie, Amgen, Biogen, Celgene, Celltrion, Ferring, Galapagos, Janssen, Lilly, Medac, MSD, Pfizer, Takeda, Theradiag
Mots-clés
Rectocolite hémorragique, colite aiguë grave, corticoïdes, ciclosporine, infliximab, colectomie
Introduction
La colite aiguë grave (CAG) peut compliquer tous les types de colites, qu’elles soient de nature infectieuse, ischémique ou inflammatoire. Pour autant, cette entité correspond classiquement à la poussée aiguë sévère de rectocolite hémorragique (RCH) comme l’indique sa dénomination (acute severe ulcerative colitis) dans la littérature internationale. C’est pourquoi nous limiterons notre propos à la CAG sur RCH.
Un tel épisode est observé chez un quart des malades atteints de RCH au cours de leur vie (1) et peut survenir à tout moment de l’évolution de la maladie. Dans plus de 25 % des cas, la CAG constitue la poussée inaugurale de la maladie (2). La pathogénie de la CAG n’est toujours pas comprise. Plus que le rôle direct de micro-organismes pathogènes tel que Clostridioides difficile (C.diff) comme facteur déclenchant de la poussée inflammatoire, l’hypothèse actuelle implique des micro-organismes commensaux pro-inflammatoires qui vont s’exprimer à la faveur d’une prédisposition génétique, d’une dysbiose pré-existante et de facteurs environnementaux à ce jour méconnus (3).
La mortalité de la CAG demeure d’au moins 1 % dans les pays occidentaux (4). À la différence de la RCH dans sa forme réfractaire non grave, l’objectif du traitement de la CAG est donc en premier lieu de sauver la vie du patient puis d’éviter la colectomie en urgence (3). Nous verrons dans la présente revue quels sont les éléments diagnostiques de la CAG et de sa prise en charge thérapeutique qui sont bien codifiés depuis plusieurs années. Ils pourraient évoluer rapidement avec des études en cours ou à venir faisant appel aux molécules les plus récentes développées dans le traitement de la RCH.
Les enjeux de la prise en charge
Dans les séries historiques du milieu du XXème siècle, antérieures à l’utilisation des corticoïdes (qui correspondent en quelque sorte à l’histoire naturelle de la CAG sur RCH), la mortalité était de plus de 30 % (5). Les contours de la prise en charge de la poussée grave de RCH tels que les a imaginés le Pr Sidney Truelove et son équipe dans les années 50, à savoir une corticothérapie courte suivie d’une colectomie de sauvetage en cas d’échec, ont permis de sauver la vie de nombreux malades. La mortalité est désormais stabilisée dans les pays occidentaux entre 1 et 2 % (4). Elle dépend en premier lieu de l’âge et du terrain du patient. Selon un audit national britannique réalisé en deux vagues en 2008 et 2010, la mortalité oscillait entre 0,1 et 0,3 % chez les patients de moins de 60 ans pour être de plus de 10 % après 80 ans (6). Le risque de décéder d’une CAG était multiplié entre 13 et 28 fois après l’âge de 60 ans. De la même manière, le taux de mortalité augmentait de 0,4 % à 2,4-4,0 % en cas de comorbidités associées. En pratique, cela signifie que les enjeux du traitement doivent tenir compte du profil du patient et de son risque de décès.
Autrement dit l’objectif sera avant tout de sauver la vie du patient chez les sujets les plus âgés et/ou comorbides et d’éviter la colectomie en urgence chez les autres. La rapidité de la prise en charge est un autre élément déterminant dans le traitement de la CAG. En effet, la morbi-mortalité de la colectomie pour RCH est directement liée à la durée d’hospitalisation préopératoire : plus celle-ci est longue et plus la mortalité postopératoire augmente (7). La prise en charge de la CAG est donc une « course contre la montre ».
Enfin, il est important d’orienter rapidement les malades vers les centres les plus expérimentés. Selon un grand registre américain, la mortalité après colectomie pour RCH était de 4 % dans les centres où cette intervention était peu pratiquée, de 2 % dans ceux faisant 4 à 11 colectomies dans l’année pour n’être plus que de 0,7 % dans ceux en réalisant au moins une par mois (7). En pratique, l’admission en gastroentérologie d’un patient ayant une CAG est un minimum et les situations les plus délicates doivent être rapidement orientées dans les centres les plus spécialisés.
Tableau 1 A : Critères de Truelove et Witts modifiés (10)
| Poussée de RCH | Légère | Sévère |
| Nombre d’évacuations par 24 h (A) | ≤ 5 | > 5 |
| Rectorragies | Traces | Importantes |
| Température (°C) | < 37°5 | ≥ 37°5 |
| Fréquence cardiaque (par min) | < 90 | ≥ 90 |
| Taux d’hémoglobine (en g/dL) | > 10 | ≤ 10 |
| Vitesse de sédimentation (en mm à la 1ère h) | < 30 | ≥ 30 |
| Albuminémie (en g/L) | > 35 | ≤ 35 |
Poussée sévère définie par A et la présence d’au moins un des six autres critères
Tableau 1 B : Critères diagnostiques pour la colite aiguë grave selon les recommandations du GETAID (8)
| Poussée sévère de RCH = | ≥ 6 évacuations sanglantes par 24h |
| Température (°C) | > 37°8 |
| Fréquence cardiaque (par min) | > 90 |
| Taux d’hémoglobine (en g/dL) | < 10,5 |
| CRP (en mg/L) | > 30 |
CRP : C-réactive protéine
Diagnostic de colite aiguë grave
La CAG est une urgence médico-chirurgicale qui relève de séquences thérapeutiques courtes. Il est donc indispensable de repérer ces malades au plus tôt sur la base de critères cliniques et biologiques simples tels qu’ils ont été établis dans les années 50 par l’équipe d’Oxford. Ils sont d’ailleurs toujours recommandés par les sociétés savantes nationales et internationales (8, 9). Ces critères sont ceux de « Truelove et Witts » qui prennent en compte à la fois l’intensité de la diarrhée sanglante et son retentissement clinique et biologique systémique. Ils pourraient être résumés de la manière suivante : une poussée de RCH constituée d’au moins 6 évacuations par 24 heures et associée à des signes généraux et/ou biologiques doit être considérée comme une CAG. Ces critères de gravité ont légèrement évolué avec le temps, puisque la C-réactive protéine (CRP) a désormais remplacé la vitesse de sédimentation et que l’albuminémie inférieure 35 g/L a été intégrée dans la version modifiée des critères de Truelove & Witts (10). Les critères définissant la CAG sur RCH sont présentés dans le tableau 1.
L’intensité des lésions endoscopiques et surtout la présence de signes de gravité que sont les ulcérations creusantes ou en puits et les décollements muqueux (Figure 1A), ne font donc pas partie des critères diagnostiques de CAG. Pour autant, il existe une association entre l’inflammation systémique et l’existence de lésions endoscopiques sévères, qui sont présentes dans 80-100 % des cas quand la C-réactive protéine (CRP) est à plus de 100 mg/L (11).
Le score de Lichtiger (Tableau 2) ne permet pas de diagnostiquer une CAG car il existe de trop nombreux faux positifs (syndrome rectal, microcolie…) et qu’il n’intègre aucun paramètre biologique qui font toute la sévérité de cette entité. Il est néanmoins admis qu’un score de Lichtiger supérieur à 10 points (sur un maximum possible de 21) est un bon reflet d’une poussée sévère de RCH. À défaut d’identifier les malades ayant une CAG, ce score clinique simple et quotidien est ensuite très utile pour suivre l’évolution des patients au jour le jour.

Figure 1 A : Signes endoscopiques de gravité au cours de la colite aiguë grave de rectocolite hémorragique : ulcérations creusantes, ulcérations en puits
Tableau 2 : Score de Lichtiger (17)
| Item | Score |
| Fréquence des évacuations (par 24h) |
| • 0–2 | 0 |
| • 3–4 | 1 |
| • 5–6 | 2 |
| • 7–9 | 3 |
| • 10 | 4 |
| Evacuations nocturnes |
| • Non | 0 |
| • Oui | 1 |
| Saignement rectal (% de nombre de selles) |
| • 0 | 0 |
| • < 50 % | 1 |
| • > 50 % | 2 |
| • 100 % | 3 |
| Incontinence fécale |
| • Non | 0 |
| • Oui | 1 |
| Douleurs abdominales |
| • Non | 0 |
| • Minime | 1 |
| • Modérée | 2 |
| • Sévère | 3 |
| Etat général |
| • Parfait | 0 |
| • Très bon | 1 |
| • Bon | 2 |
| • Moyen | 3 |
| • Mauvais | 4 |
| • Très mauvais | 5 |
| Tension abdominale à l’examen |
| • Non | 0 |
| • Légère et localisée | 1 |
| • Moyenne et diffuse | 2 |
| • Importante | 3 |
| Traitement anti-diarrhéique |
| • Non | 0 |
| • Oui | 1 |
Prise en charge à l’admission
La CAG compliquant une RCH est une urgence médico-chirurgicale qui relève d’une hospitalisation et de séquences thérapeutiques courtes. Sa prise en charge est bien codifiée.
Bilan initial
Outre les éléments biologiques initiaux ayant permis le diagnostic de CAG, des explorations simples doivent être conduites dès l’admission du patient :
- Recherche systématique de pathogènes dans les selles. Au-delà de la recherche des habituels micro-organismes, en particulier bactériens, qui peuvent occasionner une colite aiguë infectieuse, une attention toute particulière doit être portée au diff et au cytomégalovirus (CMV). Le diagnostic d’infection à C.diff repose sur la mise en évidence de sa toxine dans les selles et celui de colite à CMV sur une réplication systémique élevée sur la PCR sanguine et la mise en évidence du virus sur les biopsies coliques en anatomo-pathologie ou en immuno-histochimie. En pratique, l’instauration d’un traitement anti-CMV relève du cas par cas.
- Dépistage d’une complication : hémorragie massive, perforation ou mégacolon Le scanner abdomino-pelvien qui a désormais supplanté l’abdomen sans préparation dans cette situation est systématique. Il permet en outre d’apprécier l’étendue des lésions (Figure 1B).
- Bilan endoscopique prudent par une recto-sigmoïdoscopie sans préparation avec biopsies. Ces prélèvements permettent alors le diagnostic de RCH en cas de poussée inaugurale et la détection du La signification des signes endoscopiques de gravité (ulcérations creusantes ou en puits, décollements muqueux) (Figure 1A) qui peuvent être observés est prédictive d’une moins bonne réponse aux corticoïdes intraveineux (2, 12).
- Bilan préthérapeutique Il est à prélever dans la perspective d’un éventuel échec du traitement médical de première ligne et de recours à une deuxième ligne qui serait la ciclosporine ou l’infliximab comme nous le verrons plus loin. En l’occurrence, un bilan pré-anti-TNF doit être obtenu le plus rapidement possible et l’hypomagnésémie ou l’hypocholestérolémie doivent être recherchées et corrigées avant la mise sous ciclosporine.

Figure 1 B : ulcérations creusantes préperforatives du colon transverse observées en scanner au cours de la colite aiguë grave de rectocolite hémorragique
Traitement à instaurer dès l’admission
Comme stipulé dans les recommandations les plus récentes, une prise en charge médico-chirurgicale concertée doit être proposée d’emblée afin de confier dès l’admission au chirurgien une CAG compliquée (cf. supra) ou dépassée et de surveiller quotidiennement les autres.
En 2024, la base du traitement médical de la CAG repose toujours sur la corticothérapie intraveineuse à forte dose (au moins 0,8 mg/kg/j d’équivalent méthyl-prednisolone en une à deux fois par jour) également appelée « régime de Truelove » qui doit être initiée sans délai (9) (Figure 2). L’objectif thérapeutique est l’obtention d’une rémission clinique rapide, dans un délai de trois, maximum cinq jours.
Les autres éléments du traitement médical initial sont la prescription systématique d’héparine de bas poids moléculaire à dose préventive et l’hydratation parentérale. La mise en œuvre d’un support nutritionnel est souvent indiquée en raison de la dénutrition associée à la CAG. Un support nutritionnel entéral doit alors être privilégié car il constitue le moyen le plus efficace et le moins morbide pour traiter la dénutrition. Aussi, la nutrition entérale pourrait atténuer l’inflammation intestinale et améliorer la réponse aux corticoïdes. Un essai randomisé a en effet montré que les malades recevant une nutrition entérale exclusive en association au régime de Truelove avaient un taux d’échec à 7 jours moins élevé que ceux traités par corticoïdes sans nutrition (43 % vs. 25 % ; p=0,051) (13). À l’inverse, la nutrition parentérale totale n’a jamais démontré le moindre bénéfice sur le traitement de la poussée grave de RCH. La prescription de lavements de corticoïdes est optionnelle et dépend de l’habitude de prise en charge de chaque centre, elle n’a jamais démontré son utilité dans la CAG. Enfin, une antibiothérapie probabiliste peut être instaurée en cas de doute quant à une surinfection mais elle n’améliore pas les performances de la corticothérapie et ne doit donc pas être systématique.

Figure 2 : Vision schématique de la stratégie de prise en charge thérapeutique de la colite aiguë grave de rectocolitehémorragique
Évolution sous corticoïdes
Environ deux tiers des malades traités par corticoïdes intraveineux atteignent la rémission clinique après cinq jours de traitement (14). Le taux d’échec du régime de Truelove est donc élevé, mais aucune autre molécule n’a fait mieux depuis les années 50. L’échec de la corticothérapie, qui est confirmé après cinq jours de traitement, doit être anticipé afin de pouvoir instaurer le cas échéant un traitement de deuxième ligne au plus tôt. Ainsi, dès le troisième jour de corticoïdes, la persistance d’un nombre élevé d’évacuations par 24 heures – au moins 8 – et d’une élévation de la CRP (supérieure à 45 mg/L) prédisent l’échec du traitement (8, 9, 15).
Poussée cortico-sensible
Chez les malades en rémission clinique sous corticoïdes intraveineux, le traitement est ensuite relayé par voie orale pour être décru sur une période de 6 à 8 semaines. Le choix du traitement d’entretien à mettre en place en cas de CAG cortico-sensible reste encore très débattu. C’est avec un faible niveau d’évidence que les recommandations françaises du GETAID parues en 2022 proposent d’envisager un traitement salicylé en cas de CAG inaugurale et un traitement d’entretien par thiopurines ou biothérapie selon l’historique des échecs thérapeutiques antérieurs (8). Les résultats d’un essai randomisé du GETAID communiqué très récemment en congrès, comparant en ouvert l’azathioprine à la combothérapie infliximab + azathioprine en cas de CAG cortico-sensible, ont établi la supériorité de l’association en termes de bénéfice clinique à 12 mois chez des malades naïfs de thiopurines et d’anti-TNF (16) (Figure 3).

Figure 3 : Taux de survie sans échec du traitement à la semaine 52 (analyses en intention de traiter et en per protocole).
IFX : infliximab, AZA : azathioprine ; OR : odds ratio
Poussée cortico-résistante
En cas d’évolution cortico-résistante, l’alternative à la colectomie de sauvetage est un traitement médical de deuxième ligne. Comme nous l’avons vu plus haut, l’âge du patient et ses comorbidités sont alors des critères majeurs pour décider d’une colectomie en urgence. D’autres paramètres tels que l’ancienneté de la maladie, un doute sur la présence de dysplasie ou sur le diagnostic de maladie de Crohn, le retentissement de la poussée sur l’état général et le choix du patient seront aussi pris en compte pour décider de la colectomie au sein d’équipes médico-chirurgicales entraînées. En pratique, toute la difficulté est de confier le malade au chirurgien au bon moment : trop tôt et la colectomie peut être abusive, trop tard et la mortalité postopératoire augmente.
Traitement médical de la CAG cortico-résistante
En 2024, les options médicamenteuses possibles sont soit un inhibiteur de calcineurine, en l’occurrence plutôt la ciclosporine que le tacrolimus, soit l’infliximab (9). Quelle que soit la molécule choisie, son efficacité doit être rapidement obtenue, dans un délai de 4 à 7 jours (Figure 2). La réponse au traitement médical de deuxième ligne est définie par la baisse du score de Lichtiger à moins de 10 points deux jours consécutifs, assortie d’une amélioration du taux de CRP. Il est conseillé de maintenir les corticoïdes intraveineux à la même dose jusqu’à l’obtention d’une réponse clinique avant une décroissance rapide et aussi de prévenir la pneumocystose lorsque trois immunomodulateurs sont prescrits simultanément.
Ciclosporine intraveineuse
Depuis l’essai pionnier de Lichtiger et al ayant démontré la supériorité de la ciclosporine intraveineuse sur le placebo dans la CAG cortico-résistante, de nombreuses études, qu’il s’agisse de séries ouvertes ou d’essais contrôlés randomisés contre placebo ou infliximab, ont confirmé la très bonne efficacité de ce traitement (17) : la ciclosporine intraveineuse permet d’obtenir une rémission clinique chez plus de 80 % des patients en moins d’une semaine, (18). À ce jour, aucune autre molécule n’est plus efficace en traitement de deuxième ligne de la CAG cortico-résistante.
De nombreux effets indésirables potentiels, certains sévères, ont été observés sous ciclosporine : insuffisance rénale, hypertension artérielle, convulsions ou infections opportunistes parfois graves. Ce risque d’effet indésirable grave a diminué depuis la systématisation de plusieurs précautions telles que la prescription d’une dose initiale intraveineuse de 2 mg/kg/j au lieu de 4 mg/kg/j, la surveillance biologique régulière des taux plasmatiques, le passage précoce par la voie orale et la prévention systématique de la pneumocystose.
L’objectif du traitement de la CAG par la ciclosporine est de passer le cap en aigu pour éviter la colectomie en urgence. En raison de sa tolérance, ce traitement ne peut être envisagé qu’en induction, en cure courte, le temps que le traitement d’entretien débuté chez les malades répondeurs ait atteint son efficacité. Historiquement, cette stratégie de bridge concernait les thiopurines. Avec l’arrivée de nouvelles molécules pour traiter la RCH non grave, ces dernières années ont vu éclore de nouvelles stratégies combinant la ciclosporine avec le védolizumab ou l’ustékinumab chez des malades en CAG antérieurement exposés aux anti-TNF (cf. infra) (19).
Infliximab intraveineux
L’essai scandinave de Jarnerot et al fut le premier à démontrer que l’infliximab constituait une alternative à la ciclosporine au cours de la RCH sévère (20). Le taux de colectomie était plus faible chez les malades randomisés pour recevoir une seule perfusion d’infliximab à la dose de 5 mg/kg par rapport à ceux ayant reçu une perfusion de placebo. Comme avec la ciclosporine, de nombreuses séries observationnelles ont depuis confirmé l’efficacité de l’infliximab au cours de la CAG sur RCH. Le taux de malades répondeurs est d’environ 80 %, autrement dit voisin de celui de la ciclosporine. En termes de tolérance, plusieurs complications infectieuses graves bactériennes ou à germes opportunistes ont également été observées sous infliximab.
Des arguments pharmacologiques laissent penser qu’il faudrait avoir recours à des doses d’infliximab plus importantes dans la CAG qu’au cours de la RCH non grave : clairance accélérée en raison d’une charge inflammatoire élevée et de l’hypoalbuminémie, excrétion fécale de la molécule, formation précoce d’anticorps anti-médicament (21, 22). Pour autant, les séries publiées à ce jour et une méta-analyse n’ont pas confirmé que des doses supérieures à 5 mg/kg et/ou des perfusions plus rapprochées qu’aux semaines 0-2-6 étaient en mesure de réduire le taux de colectomie initiale (23). Deux essais randomisés comparant des doses standards à des doses intensifiées d’infliximab sont en cours.
Tableau 3 : Efficacité comparée de la ciclosporine et de l’infliximab en traitement de la poussée sévère de rectocolite hémorragique (essais contrôlés randomisés)
| Ciclosporine | Infliximab |
| Taux de réponse à 7 jours* (%) | 86 | 84 |
| Taux d’échec du traitement à 3 mois* (%) | 60 | 54 |
| Taux de rémission endoscopique à 3 mois* (%) | 47 | 45 |
| Taux de colectomie à 3 mois* (%) | 17 | 21 |
| Taux de colectomie à long terme (5 ans)* (%) | 38 | 35 |
| Taux de colectomie à long terme** (%) | 47 | 39 |
* : essai CYSIF (18, 24)
** : essai CONSTRUCT (25)
Ciclosporine ou infliximab ?
En 2024, il est toujours bien difficile de choisir entre la ciclosporine et l’infliximab en traitement de deuxième ligne de la CAG cortico-résistante. Les deux essais contrôlés randomisés qui ont directement comparé ces molécules entre elles n’ont pu démontrer qu’un traitement était supérieur à l’autre, que ce soit à la phase initiale ou bien à moyen, voire plus long terme (18, 24, 25). Les principaux résultats de ces essais et de leur suivi à distance sont synthétisés dans le tableau 3. Deux subtiles différences plaident en faveur de l’infliximab : un délai médian de réponse raccourci d’un jour (4 au lieu de 5) et un taux de cicatrisation endoscopique complète définie par un sous-score Mayo de 0 plus élevé à trois mois (26).
Au-delà des données d’efficacité et de tolérance qui sont très voisines entre les deux molécules, ce sont d’autres critères, tels que la voie d’administration, la maniabilité, l’habitude mais aussi le coût qui vont guider le choix du prescripteur. Loin d’être figés, ces éléments ont évolué dernièrement : le suivi pharmacologique rapproché indispensable avec la ciclosporine s’est également répandu avec l’infliximab, la différence de coût entre les deux traitements s’est réduite depuis le recours aux biosimilaires de l’infliximab et cet anti-TNF est maintenant disponible par voie sous-cutanée.
Enfin, les deux éléments stratégiques à court et moyen termes à prendre en compte au moment de choisir entre ciclosporine et infliximab sont la possibilité d’un éventuel traitement de troisième ligne de la CAG qui, comme nous le verrons plus loin, doit être réservée à des cas particuliers, et la durée du traitement qui sera de quelques semaines avec la ciclosporine mais bien plus prolongée avec l’infliximab sachant qu’il faudra y associer au départ un immunosuppresseur conventionnel.
Traitement de troisième ligne ?
Lorsque deux lignes de traitement médical ont échoué, la colectomie est recommandée (8, 9) (Figure 2). La morbi-mortalité de la colectomie de sauvetage reste en effet acceptable lorsqu’elle est pratiquée dans un délai de 10 à 12 jours après le début de l’hospitalisation et s’accroit par la suite. Chez des malades très sélectionnés, jeunes et motivés, à faible risque de mortalité (cf. supra), un traitement de sauvetage peut être discuté. Il consiste alors à proposer l’infliximab après échec de la ciclosporine ou bien la séquence inverse. Dans une synthèse récente compilant les résultats de 23 études ayant analysé 340 malades, 53 % des malades traités par une troisième ligne évitaient la colectomie (19). Il n’y avait pas de différence selon la séquence thérapeutique proposée (ciclosporine puis infliximab ou l’inverse). En revanche, 26 % des malades développaient un évènement indésirable et trois (0,88 %) décès étaient constatés. Autrement dit, les risques, notamment en termes d’infection sévère et opportuniste, à empiler les traitements immunomodulateurs chez des patients graves et souvent dénutris permet d’éviter une colectomie sur deux. En pratique, un traitement de troisième ligne ne peut s’envisager qu’en centre expert, chez des malades très sélectionnés, jeunes et parfaitement informés des risques encourus. Il semble alors plus raisonnable pour des raisons pharmacologiques que de proposer l’infliximab après échec de la ciclosporine que de proposer la séquence inverse.
Vers de nouvelles stratégies de prise en charge ?
Les options thérapeutiques disponibles pour traiter la RCH réfractaire sont devenues nombreuses. Nous disposons de trois anti-TNF (infliximab, adalimumab et golimumab), d’un anti-intégrine (védolizumab), d’un anti-interleukine (IL) 12/23 (ustékinumab), d’anti-IL23 spécifiques (mirikizumab et bientôt risankizumab et guselkumab) et de trois inhibiteurs de Janus kinases (iJAK) (tofacitinib, filgotinib et upadacitinib). Il faut rappeler que les essais pivots ayant permis à ces molécules d’obtenir leur remboursement ont systématiquement exclu les patients hospitalisés pour CAG. Le seul traitement ciblé ayant démontré son efficacité dans cette indication reste donc l’infliximab.
Pour autant, la survenue d’un épisode de CAG chez des patients déjà exposés aux anti-TNF et en particulier à l’infliximab est devenue de plus en plus fréquente. De nouvelles stratégies ont donc émergé dans cette situation sans qu’aucune n’ait vraiment été validée à ce jour.
Anticorps monoclonaux
Le védolizumab et les anti-IL-12/23 et IL-23 ont un délai d’action qui n’est pas assez rapide pour répondre à l’urgence thérapeutique de la CAG. Ces dernières années ont ainsi vu éclore de nouvelles stratégies chez des malades en échec d’anti-TNF, réfractaires aux corticoïdes intraveineux, combinant la ciclosporine en traitement d’induction avec le védolizumab ou l’ustékinumab en traitement d’entretien.
La combinaison entre un inhibiteur de calcineurine et le védolizumab a été évaluée dans sept séries ayant inclus 145 malades (14, 15). Les taux de survie sans colectomie et d’évènement indésirable grave étaient respectivement de 69 % et de 1,8 % pour une mortalité nulle (19). Ces données suggèrent qu’un traitement par ciclosporine en bridge pour le védolizumab est envisageable en cas d’échec antérieur des anti-TNF (3).
Les données concernant l’ustékinumab en traitement de la CAG sont plus minces encore. Trois séries rétrospectives pour un total de 13 malades ont évalué l’intérêt à combiner un inhibiteur de calcineurine à l’ustékinumab chez des malades en échec des anti-TNF et du védolizumab. L’efficacité était bonne puisqu’aucun des malades traités n’a été colectomisé pour une tolérance acceptable (19). Il n’existe pour le moment aucune donnée avec les anti-IL23 spécifiques dans la CAG.
Inhibiteurs de Janus kinases
Les iJAK ont un délai d’action rapide, de l’ordre de quelques jours, qui en font des candidats sérieux pour traiter des patients en CAG. Le tofacitinib a ainsi été testé chez des malades hospitalisés pour une poussée sévère de RCH cortico-résistante voire chez des patients admis pour une authentique CAG. Dans la série de l’Université du Michigan de 40 malades ayant une CAG cortico-résistante, le taux de colectomie à 90 jours était de 15 % (27). Dans la série française du GETAID, le taux de colectomie à 3 mois était de 21 % parmi les 55 malades admis pour une poussée sévère de RCH cortico-résistante (28). Dans la revue de Gisbert et al, reprenant les données des 134 malades traités par tofacitinib, le taux de survie sans colectomie était de 77 % (19).
D’après l’expérience de Berinstein et al, la dose initiale de 10 mg trois par jour de tofacitinib pourrait être plus efficace en traitement de la CAG que celle de 10 mg deux fois par jour sans surcroit d’effets indésirables (27). Des essais randomisés ont débuté pour évaluer l’efficacité du tofacitinib en traitement de première ligne de la CAG en combinaison avec les corticoïdes intraveineux ou bien en deuxième ligne en comparaison avec la ciclosporine.
Les données concernant l’upadacitinib en traitement de la CAG se limitent à une série australienne récente de six malades dont cinq ont pu éviter la colectomie (29). Il n’existe pour le moment aucune publication sur le filgotinib dans cette indication.
En l’absence d’essai contrôlé validant l’efficacité des iJAK et plus particulièrement du tofacitinib dans la CAG, le recours à cette classe thérapeutique doit être prudent et privilégié en centre expert.
Traitement chirurgical
La prise en charge de la CAG se doit d’être médico-chirurgicale dès l’admission (9). La colectomie de sauvetage est en effet à discuter à chaque étape du traitement.
La chirurgie demeure le traitement historique de la CAG en échec du traitement médical. Son principe est simple, sacrifier un organe pour sauver la vie du patient. Comme mentionné précédemment, une colectomie pour RCH doit être réalisée en centre expert.
Les modalités de cette intervention ont beaucoup évolué au cours des dernières années. La chirurgie de la CAG est une chirurgie d’urgence pour laquelle l’abord laparoscopique doit toujours être privilégié. Les suites opératoires sont plus simples et plus courtes et il n’y a pas de conséquence sur la fertilité chez la femme. L’intervention consiste en une colectomie subtotale sans anastomose, avec iléostomie terminale et sigmoïdostomie (3). La pièce de colectomie est extraite par l’orifice d’iléostomie et le segment recto-sigmoïdien d’aval ancré en canon de fusil au niveau de l’orifice d’iléostomie ou à défaut en région sus-pubienne, ce qui permettra d’y pratiquer des instillations en postopératoire.
En 2024, l’intervention de référence de la RCH reste la colo-proctectomie totale avec anastomose iléo-anale (AIA) qui sera réalisée à distance de la prise en charge en aigu, toujours par voie laparoscopique. La séquence habituelle se fait en trois temps : colectomie en urgence suivie 2-3 mois plus tard d’une proctectomie avec confection de l’AIA protégée par une iléostomie, suivie 2-3 mois plus tard de la fermeture de l’iléostomie d’amont. Une stratégie dite « en deux temps modifiée » est actuellement en cours d’évaluation. Elle consiste à réaliser la deuxième étape sans iléostomie de protection. L’abord mini-invasif par mono-trocart et la chirurgie robotique sont en cours d’évaluation dans la RCH.
Le résultat fonctionnel après AIA ne peut être prédit avant l’intervention. Il dépend beaucoup de l’expertise de l’équipe de chirurgie colorectale. In fine, les malades ayant une AIA ont en médiane 6-7 selles par 24 h, près de la moitié d’entre eux doivent se lever au moins une fois la nuit et environ 20 % signalent une incontinence fécale invalidante (30).
Les complications postopératoires à long terme concernent un tiers des malades : l’incidence de la pochite est estimée à 29 % et celle de l’occlusion à 17 %. La proportion de malades qui nécessiteront à terme une iléostomie définitive est d’environ 5 % (3, 30). Les avancées en chirurgie colorectale, que ce soient la mise en condition préopératoire, la nutrition entérale péri-opératoire, l’abord laparoscopique et la réhabilitation précoce, ont permis de réduire depuis 2010 les taux d’infections précoces, d’occlusion sur bride et d’iléostomie définitive.
Dans de rares cas, une conservation du rectum est possible. La colectomie subtotale avec anastomose iléo-rectale alors envisagée a un meilleur pronostic fonctionnel que celui de l’AIA. Les conditions qui permettent une conservation rectale sont l’absence de lésion muqueuse inflammatoire significative ou de dysplasie rectale en préopératoire, une compliance normale et que le malade accepte le principe d’une surveillance endoscopique à long terme.
Conclusion
La CAG constitue une urgence médico-chirurgicale qui doit être hospitalisée sans délai dans une unité spécialisée. La prise en charge fait appel à des séquences thérapeutiques médicamenteuses courtes et à la colectomie de sauvetage en cas d’échec ou de complication. Une mise en relation avec les équipes les plus expérimentées dans le domaine est indispensable, de manière à proposer la meilleure séquence thérapeutique sans différer une indication de colectomie en urgence dont la mortalité augmente avec la durée du traitement médical et diminue dans les centres de référence.
En 2024, la stratégie de traitement de la CAG est bien codifiée. Mais le développement de nouvelles molécules dans le traitement de la RCH laisse entrevoir de nouvelles possibilités avec les iJAK ou en combinant la ciclosporine et des anticorps monoclonaux. L’avenir nous dira si des paradigmes anciens tels que la corticothérapie intraveineuse en première ligne ou le recours à la ciclosporine intraveineuse chez les cortico-résistants peuvent être remis en question. À l’heure actuelle, le niveau de preuve pour traiter un malade admis en CAG avec ces nouvelles molécules est encore faible. L’essor des traitements dans la RCH ne doit donc pas occulter l’enjeu numéro un de la CAG qui doit être celui d’une mortalité nulle, ce qui sous- entend que toutes les colectomies ne pourront pas être évitées.
Références
- Dinesen LC, Walsh AJ, Protic MN, et The pattern and outcome of acute severe colitis. J Crohns Colitis 2010;4:431-7.
- Adams A, Gupta V, Mohsen W, et Early management of acute severe UC in the biologics era: development and international validation of a prognostic clinical index to predict steroid response. Gut 2023; 72: 433-42.
- Rivière P, Li Wai Suen C, Chaparro M, et Acute severe ulcerative colitis management: unanswered questions and latest insights. Lancet Gastroenterol Hepatol 2024 (in press)
- Dong C, Metzger M, Holsbø E, et al. Systematic review with meta-analysis: mortality in acute severe ulcerative Aliment Pharmacol Ther. 2020 Jan;51(1):8-33.
- Truelove SC, Witts Cortisone in ulcerative colitis; final report on a therapeutic trial. Br Med J 1955;2:1041-8.
- Lynch RW, Lowe D, Protheroe A, et Outcomes of rescue therapy in acute severe ulcerative colitis: data from the United Kingdom inflammatory bowel disease audit. Aliment Pharmacol Ther. 2013 Oct;38(8):935-45.
- Kaplan GG, McCarthy EP, Ayanian JZ, Korzenik J, Hodin R, Sands Impact of hospital volume on postoperative morbidity and mortality following a colectomy for ulcerative colitis. Gastroenterology 2008;134:680-7.
- Amiot A, Viennot S, Uzzan M, et al. Recommandations de pratique pour le diagnostic et la prise en charge de la rectocolite hémorragique. HGOD Volume 29, numéro 3, Mars 2022.
- Spinelli A, Bonovas S, Burisch J, et ECCO Guidelines on Therapeutics in Ulcerative Colitis: Surgical Treatment. J Crohns Colitis 2022; 16: 179–89.
- Chapman RW, Selby WS, Jewell Controlled trial of intravenous metronidazole as an adjunct to corticosteroids in severe ulcerative colitis. Gut 1986;27:1210-2.
- Rivière P, Le Chevillier A, Rullier A, et Deep ulcers are associated with increased C-reactive protein in active ulcerative colitis. Dig Liver Dis 2023; published online May 25. DOI:10.1016/j.dld.2023.05.004.
- Grant RK, Jones G-R, Plevris N, et The ACE (Albumin, CRP and Endoscopy) Index in Acute Colitis: A Simple Clinical Index on Admission that Predicts Outcome in Patients With Acute Ulcerative Colitis. Inflamm Bowel Dis 2021; 27: 451-4.
- Sahu P, Kedia S, Vuyyuru SK, et al. Randomised clinical trial: exclusive enteral nutrition versus standard of care for acute severe ulcerative colitis. Aliment Pharmacol Ther. 2021;53:568-576.
- Turner D, Walsh CM, Steinhart AH, Griffiths Response to Corticosteroids in Severe Ulcerative Colitis: A Systematic Review of the Literature and a Meta-Regression. Clin Gastroenterol Hepatol 2007; 5: 103–10.
- Travis SP, Farrant JM, Ricketts C, Nolan DJ, Mortensen NM, Kettlewell MG, et Predicting outcome in severe ulcerative colitis. Gut 1996;38:905-10.
- Amiot A, Seksik P, Meyer A, et al. Infliximab plus azathioprine and quick steroids discontinuation versus azathioprine plus steroids in patients with acute severe ulcerative colitis responding to intravenous steroids: a parallel, open-label randomized controlled trial. UEGW 2023. OP.
- Lichtiger S, Present DH, Kornbluth A, Gelernt I, Bauer J, Galler G, et Cyclosporine in severe ulcerative colitis refractory to steroid therapy. N Engl J Med 1994;330:1841-5.
- Laharie D, Bourreille A, Branche J, et Ciclosporine versus infliximab in acute severe colitis refractory to intravenous steroids: a randomized study. Lancet 2012; 380: 1909-15.
- Gisbert JP, García MJ, Chaparro Rescue therapies for steroid-refractory acute severe ulcerative colitis: A review. J Crohns Colitis 2023; 17: 972-94.
- Jarnerot G, Hertervig E, Friis-Liby I, Blomquist L, Karlen P, Granno C, et al. Infliximab as rescue therapy in severe to moderately severe ulcerative colitis: a randomized, placebo-controlled study. Gastroenterology 2005;128:1805-11.
- Brandse JF, van den Brink GR, Wildenberg ME, et Loss of Infliximab Into Feces Is Associated With Lack of Response to Therapy in Patients With Severe Ulcerative Colitis. Gastroenterology. 2015 Aug;149(2):350-5.e2.
- Poullenot F, Nivet D, Paul S, et al. Severe endoscopic lesions are not associated with more infliximab fecal loss in acute severe ulcerative colitis. Dig Liver Dis. 2018; 50: 1100-3.
- Nalagatla N, Falloon K, Tran G, et al. Effect of Accelerated Infliximab Induction on Short- and Long-term Outcomes of Acute Severe Ulcerative Colitis: A Retrospective Multicenter Study and Meta-analysis. Clin Gastroenterol Hepatol. 2019 Feb;17(3):502-509.e1.
- Laharie D, Bourreille A, Branche J, et Long-term outcome of patients with steroid-refractory acute severe UC treated with ciclosporin or infliximab. Gut 2018;67:237–243.
- Williams JG, Alam MF, Alrubaiy L, et Infliximab versus ciclosporin for steroid-resistant acute severe ulcerative colitis (CONSTRUCT): a mixed methods, open-label, pragmatic randomised trial. Lancet Gastroenterol Hepatol 2016;1:15–24.
- Laharie D, Bourreille A, Branche J, et Evolution of Endoscopic Lesions in Steroid-Refractory Acute Severe Ulcerative Colitis Responding to Infliximab or Cyclosporine. Clin Gastroenterol Hepatol. 2021; 19: 1180-8.
- Berinstein JA, Sheehan JL, Dias M, et Tofacitinib for Biologic-Experienced Hospitalized Patients With Acute Severe Ulcerative Colitis: A Retrospective Case-Control Study. Clin Gastroenterol Hepatol. 2021;19:2112-2120.
- Uzzan M, Bresteau C, Laharie D, et Tofacitinib as salvage therapy for 55 patients hospitalised with refractory severe ulcerative colitis: A GETAID cohort. Aliment Pharmacol Ther. 2021;54:312-319.
- Gilmore R, Tan L, Fernandes R, An Y-K, Begun Upadacitinib Salvage Therapy for Infliximab experienced patients with Acute Severe Ulcerative Colitis. J Crohns Colitis 2023. doi: 10.1093/ecco-jcc/jjad115. Online ahead of print.
- Peyrin-Biroulet L, Germain A, Patel AS, Lindsay Systematic review: outcomes and post-operative complications following colectomy for ulcerative colitis. Aliment Pharmacol Ther 2016; 44: 807–16.